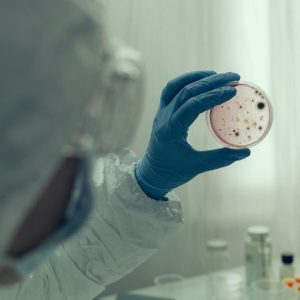

EN CE MOMENT
14 avril 2026
14 avril 2026
14 avril 2026
choléra